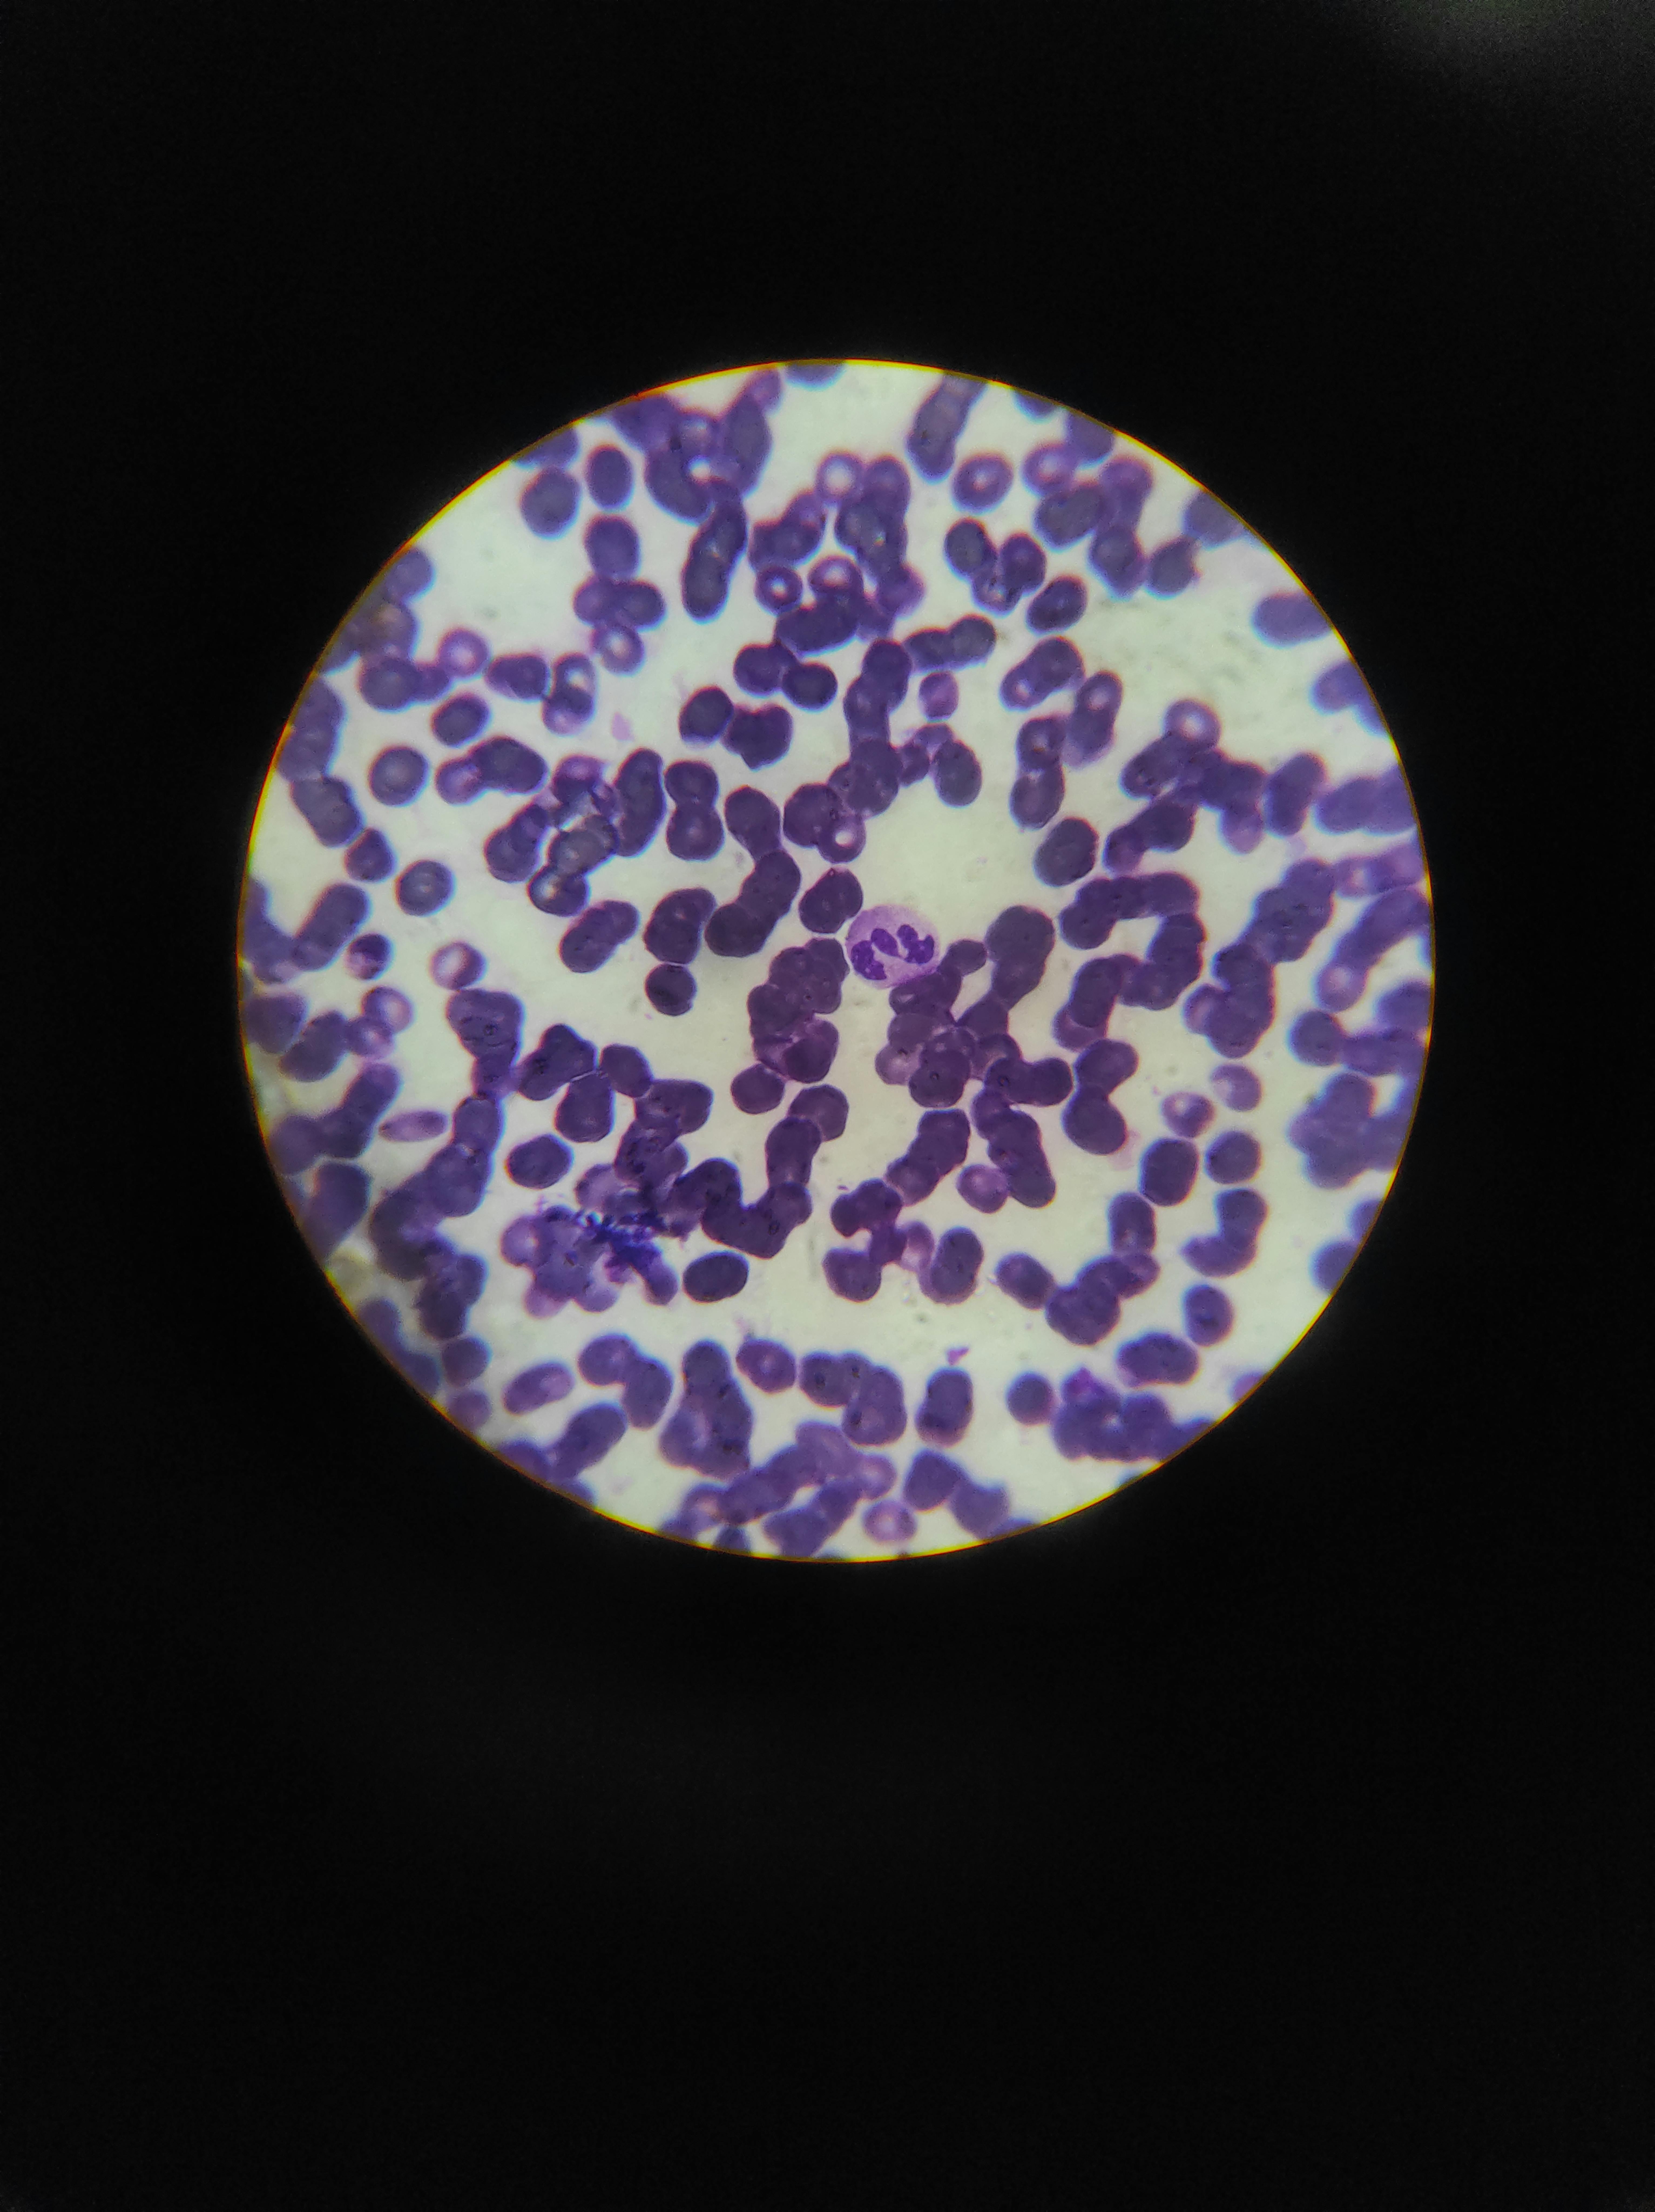

Research Publications and Clinical Trials


DNA methylation profiling of buccal cells across smoking, vaping, and exercise groups identified distinct DMRs per behavior—11 unique to vapers vs. non-users and 28 divergent between smokers and vapers—establishing lifestyle-specific epigenetic fingerprints with applications in personalized health assessment and forensic behavioral inference.

Integrating AI facial scores with skin DNA methylation from 706 people, EpiVision offers 21 epigenetic predictors spanning structural (wrinkles), pigmentary, inflammatory, and textural aging—revealing hormonal, UV, and epithelial remodeling pathways, and capturing lifestyle-and treatment-associated variation for evaluating skin-aging interventions.

Using a 19-subtype DNA methylation panel, age-related monocyte shifts—rising "old" vs. "young" fractions—independently predict inflammaging and all-cause mortality beyond standard risk factors. Rare red blood cell precursors also emerged as an independent mortality signal, extending the aging-immune axis into innate and erythroid compartments.

Defective XCI—when >10% of cells fail to silence the second X—carries ~40% cancer risk across 12 tumor types. In breast cancer, it raises triple-negative frequency, reduces survival, and partly reverses with chemotherapy. X-Ra is a blood biomarker detecting defective XCI non-invasively, linking it to cancer, aging, and menopause.

The largest MWAS of alcohol use (13,970 participants) identified 1,266 significant CpG sites in whole blood, replicated in an independent cohort. Deconvolution across 12 blood cell types revealed cell-specific methylation patterns, showing how alcohol reshapes the epigenome and drives hypertension and health risks.

Built from ~31,000 biobank records, EMRAge—a mortality-linked biological age from routine labs—was modeled as DNAmEMRAge and OMICmAge. Both outperform existing clocks across three validation cohorts (n > 36,000), integrating the epigenome, proteome, and metabolome into a single estimate from blood methylation alone.
36-color spectral flow cytometry (donors aged 20–82) identified CXCR3-negative CD8 memory T cells that accumulate with age, shifting to a Th2-like (type 2) cytokine profile—backed by transcriptomic and epigenetic data—and linked to asthma, chronic liver disease, and type 2 diabetes, tying an age-driven immune shift to multiple chronic conditions.

Epigenetic clocks trained on senescence-linked CpG sites showed no reversal after senolytic treatment—not in cell culture, human trials, or mouse models. Clearing "zombie cells" leaves their methylation marks intact, raising questions about using clock-based outcomes to evaluate senolytic interventions.

TruDiagnostic received an NIH SBIR grant to develop the W-Function Epigenomic Roadmap, a dynamic model that maps how DNA methylation changes over time to predict and prevent chronic disease. The framework aims to improve early detection, guide personalized treatment, and accelerate therapeutic discovery.

New EPICv2 methylation array boosts enhancer coverage, works with diverse ancestries and as little as 1 ng DNA, and still delivers accurate, reproducible data. It supports clocks, deconvolution, trait CpGs, and maps DNMT/SETD2 mutation signatures, providing a versatile tool for epigenetic studies.

In 83 spinal-deformity patients, faster epigenetic aging (DunedinPACE™, PhenoAge, GrimAge) tracked with greater frailty/disability, while shorter telomeres flagged 90-day complications—supporting biological-age markers to refine surgical risk.

In 94 patients ≥60 y with blood cancers, T-cell PhenoAge topped healthy controls, highest in acute leukemia. Greater epigenetic age tied to poorer ECOG, IADL loss and comorbidities, while hypomethylating therapy lowered PhenoAge, hinting reversibility.

Researchers created and validated a DNAm reference for 12 blood immune cells, then profiled 23,053 samples. Sex, age, smoking, obesity, exercise and sleep altered cell fractions; more naïve CD4+ T and NK cells predicted lower all-cause mortality.

Hefty alcohol and tobacco use tweaks hundreds of gene “switches”; 66 alcohol-linked changes largely explain its boost to high blood pressure, while marijuana shows little effect.

Blood DNA-methylation study (86 BD, 39 matched controls) shows bipolar patients age faster per DunedinPACE™. Faster pace is largely mediated by DNAm surrogates of metabolic, anthropometric and inflammatory traits; within BD, worse metabolic profiles track higher aging pace.

Prospective study of 43 adult spinal-deformity patients: blood epigenetic clocks and telomere length were compared with frailty, comorbidities, disability, and 90-day complications. Epigenetic age linked to CCI, ASD-FI; shorter telomeres predicted post-op complications, enhancing risk tools.

In 12 mid-aged adults, 12-wk NAD3 (wasabi extract + theacrine + copper niacin) shifted 64 PBMC mRNAs, curbed CpG hypermethylation, and prevented the placebo-linked drop in sirtuin activity, paralleling higher NAD+/NADH. NAD3 may preserve DNA structure and sirtuin function, pending larger trials.

In 1,044 HELIX kids, a prenatal exposome combo—low dairy, non-smoker cotinine, low facility richness, ample greenspace—defined Environment E1. There, girls (not boys) showed sharply lower obesity and neurodevelopment-delay risk, echoed by DNA-methylation shifts.

In 11 trained men, squats/leg extensions to failure at 30 % or 80 % 1-RM (volume-matched) triggered similar muscle DNA-methylation and mRNA shifts—major at 3 h, fewer at 6 h—engaging focal-adhesion, MAPK and PI3K-Akt pathways alike, showing load doesn’t dictate early epigenetic response.

In 11 trained men, squats/leg extensions to failure at 30 % or 80 % 1-RM altered hypertrophy-related gene expression similarly: 32/58 mRNAs shifted 3 h, 17 at 6 h, with myostatin-pathway genes most affected. p70S6K and follistatin proteins rose, highlighting load-independent myostatin regulation.

Blood DNA methylation tracked pre/post mild COVID-19 (n=21) found 756 CpG shifts and age-split clock shifts: PhenoAge/GrimAge rose in >50 yr, fell in younger adults. In 36 others, Moderna vaccine cut Horvath age by ~3.9 yr (>50). Epigenetic clocks could monitor infection and vaccine effects.

In 11 trained men, a single squat + leg-extension bout to failure at 80 % or 30 % 1-RM (matched volume) reshaped promoter methylation of ~46 hypertrophy genes; the heavier load yielded distinct hypomethylation patterns, revealing load-specific epigenetic drivers of muscle adaptation.

Eleven trained men did squat + leg extensions to failure at 80 % vs 30 % 1-RM. The 30 % load yielded far more reps but matched volume. Both sessions cut global DNA methylation 3–6 h post-exercise, with a larger drop trending after 30 %, hinting low-load RT drives stronger muscle hypomethylation.

ARDD 2021 (Aug 30–Sep 3) drew 130 onsite and 1,800 online participants. Seventy-five talks covered aging mechanisms, modulating interventions, AI-driven discovery and research standards; a new longevity workshop linked scientists with clinicians.

Phase-I: 19 adults on dasatinib + quercetin (DQ) for 6 months showed faster epigenetic/mitotic aging and shorter telomeres. Adding fisetin (DQF) for 6 mo in 19 subjects blunted age acceleration and shifted immune-cell mix, hinting fisetin may counter DQ’s pro-aging epigenetic effects.

22,819-probe Human Imprintome array profiles 1,088 of 1,488 candidate ICRs, filling gaps left by standard Infinium chips at lower cost. Methylation concordance: R² 0.569 vs WGBS, 0.796 vs EPIC v2; replication ICC 0.80–0.95. Delivers reliable, scalable ICR analysis.

In 86 adult spinal-deformity patients, blood epigenetic clocks—especially DunedinPACE™—tied faster biological aging to greater frailty (EFS, ASD-FI), worse disability (ODI, SRS-22) and more 90-day complications, suggesting biological age can refine surgical risk prediction.

Methylation of specific HERV and LINE-1 loci forms potent epigenetic clocks across tissues and species. These clocks reset with reprogramming, accelerate in HIV-1, respond to therapy, and track brain organoid age, tying retroelement control to aging.

WGBS of germ-layer tissues and gametes mapped 1,488 hemi-methylated candidate imprint control regions, including 19/25 known. 332 showed near-complete parent-specific methylation and 65 % overlapped CTCF/DNase sites. This draft imprintome opens paths to study imprinting errors in disease.

In an 8-week twin study, only the vegan diet cut epigenetic age: lower PC GrimAge, PC PhenoAge, DunedinPACE™ and reduced aging in inflammation, heart, hormone, liver and metabolic systems. Omnivores didn’t shift, underscoring plant-based diets’ anti-aging edge.

Simulating DNAm drift in >22k blood samples shows stochastic change explains 66–75 % of Horvath clock accuracy, 90 % for Zhang, but 63 % for PhenoAge, implying true aging reflects non-stochastic biology. Male, severe COVID-19 and smoker accelerations stem from these non-random effects.

Using blood DNA methylation with machine learning, we built 11 system-specific epigenetic clocks (Heart, Lung, Kidney, etc.) plus a unified Systems Age. These scores predict system-level aging, mortality and disease, revealing distinct aging subtypes for personalized care.

This genome-wide association study using mass spectrometry-based proteomics identifies and replicates novel protein quantitative trait loci (pQTLs), highlights biases from affinity-based methods, and demonstrates the broader potential of MS platforms to uncover new drug discovery targets.

In 99 US participants from the REPRIEVE trial, pitavastatin prevented an increase in the pace of biological aging—measured by DunedinPACE—over 24 months, while the placebo arm showed a significant rise (P = .049). These findings suggest statin therapy may counteract the accelerated epigenetic aging commonly seen in people living with HIV, supporting further investigation into statins as longevity interventions in this population.

SRW Laboratories has formulated the Cel System protocol, a group of three formulas designed to interact with each of the 9 Hallmarks of Aging and combined this with an App that supports positive lifestyle changes, with a view that, if we can positively impact each Hallmark, we can support healthy aging. Each of the formulas is based on natural ingredients. Their year-long project evaluated the impact of this regimen on the nine hallmarks of aging. In addition to the investigational product (Cel1, Cel2, Cel3), participants were asked to use a proprietary phone app designed to support positive lifestyle factors such as mindfulness and exercise. For this study, patients had check-ins at baseline, 3 months, 6 months, and 12 months. In addition to methylation testing at each timepoint, patients also had physiologic measurements taken and completed a quality of life questionnaire. The data collection part of this study was recently completed and now our bioinformatics team is working on it! Check back for more information on the results of this study!

Potential health impacts of EMF exposure are a growing concern, particularly with the exponential increase and pervasive use of transmitting technologies in recent decades, including wireless. Evidence regarding the means by which adverse effects may be successfully mitigated is sparse. Blushield technology, which simultaneously emits multiple coherent frequencies within the human responsive range to compete with non-native ambient EMFs, is a newly developed and potentially superior protection alternative to those acting via direct blockade. This cohort study involved a 12-week intervention period of continuous resonance-based electromagnetic field (EMF) protection device usage flanked by pre- and post-intervention biological sampling (blood and saliva) for multimodal molecular assessments. Additional outcome measures included clinical assessments by self-report questionnaires regarding health history, functional and neurocognitive status, symptoms, and continuous passive physiological monitoring using an Oura ring. Study Findings: Study findings with respect to epigenetic aging revealed no difference in epigenetic age before and after device usage.

Biological clocks have shown associations to many aging outcomes, this includes facial aging. In a clock exclusively developed by TruDiagnostic, we have shown that the rate of biological aging is predictive of skin aging. In collaboration with Olaplex, we are working to create a tool that can help determine the best products for different skin types based on DNA methylation. The purpose of this project is to evaluate the relationship between skin aging and biological aging, by comparing skin images with skin scrapings that have undergone DNA methylation testing. Skin images reveal metrics such as eye age and bags, lines, redness, and uniformness among others. These data will be correlated with data from methylation testing of skin scrapings.

Data suggest that a large percentage of Americans do not meet the recommended intakes of several vitamins and minerals present in vegetables. Plant-based diets rich in vegetables, legumes, nuts and seeds, fruits, and whole grains have been associated with a reduction in the risk of cardiovascular disease, diabetes, and cancers. Additionally, plant-based diet intervention studies have reported improved mental health and quality of life indicators. The Nutritarian diet is a plant-based diet that emphasizes specific foods with evidence for antioxidant, anti-inflammatory, cardioprotective, and anti-tumor properties and aims for a low-to- moderate glycemic load. Beans and other legumes are emphasized because of their high fiber and resistant starch content. The primary purpose of this study is to compare multiple DNA methylation age indicators between a group of participants following the standard American diet to a group of participants who have followed the Nutritarian diet for at least five years.

This was a prospective non-randomized study of 20-25 patients over age 40 to evaluate the effects Quercetin and Dasatinib have on healthy individuals over a 6-month period. Previous evidence that Quercetin and Dasatinib slows cell proliferation and decelerates aging and the risk of age-related diseases. The aim of the pilot study is to evaluate the safety, efficacy and feasibility of Quercetin and Dasatinib as an effective treatment option to improve the clinical care of healthy individual’s epigenetic aging rate and, thus, prolong longevity. Aging will be measured by DNA methylation with TruDiagnostic. Patients will also have a complete blood panel and immune cell subset run before starting the study and after it is completed. Methylation testing is more accurate for determining the biological rather than chronological age of a person. Some people are epigenetically older or younger than their chronological age, meaning that their rate of aging is accelerated or decelerated from the rate we measure their age by years. Such a method of measurement is therefore ideal for measuring changes to biological age in order to test the interventions of Quercetin and Dasatinib as they target the aging processes.

Adventa Bioscience conducted a study to examine the impact of a human breast milk, Trulacta, supplement on epigenetic and cellular markers. Human breast milk has been widely studied in babies, as have certain elements of breastmilk in adults. None of those studies, however, address the effectiveness of raw breastmilk in adults. Furthermore, Adventa Bioscience’s proprietary process of converting breastmilk into a powder which is then encapsulated has not been studied. Early customers of the breastmilk capsule, Trulacta, have experienced promising results; from increased sleep, reduced pain and bloating, and reduction or elimination of symptoms caused by severe diseases. The objective of this study is to understand the impact of a human breast milk supplement on measurements of epigenetic cell patterns over a 90-day period. The secondary objectives are to evaluate how Trulacta affects sleep, inflammation, anti-aging, immuno-modulation and metabolic health as measured by serum biomarkers, clinical parameters and validated questionnaires. In addition to methylation testing, patients completed the Pittsburgh Sleep Quality index to determine effects on sleep quality in participants. Study Findings: Study findings did not show a change in epigenetic age with this supplement. Given the small sample size and limited time of treatment, further studies may be warranted to determine if this supplement is effective.

This was a prospective non-randomized clinical study of 24 patients to evaluate the effects of the patented extract of Uncaria tomentosa trade name, AC-11®,also referred to as “Supplement,” owned by Optigenex Inc. The aim of the study is to document the effectiveness of AC-11 in reversing epigenetic markers of biological age and to gather epigenetic data to show the origin of the extracts' effect on telomere length. The duration of the study was 6 months; patients had TruAge testing at baseline and after the study completion. Twenty-four participants were enrolled, age 55 and above, and in good health. In addition to TruAge testing at baseline and the study endpoint, patients also had an oxidative stress panel, telomere test, CBC, and C-reactive protein drawn.

While current research has identified many mechanisms of action, effects and cell signaling changes resulting from hyperbaric oxygen therapy (HBOT), we do not have a firm understanding of the timeframe and dosage for many of these expected adaptations. The design of this research project will help to not only confirm these cell-signaling changes and benefits but to also develop a better understanding of the necessary PO2 and time frame required in order to achieve these changes leading to improved patient outcomes in our field. This is a prospective, double-blind crossover, single site study that will include 30 subjects. The purpose of the study is to evaluate the clinical impact of different PO2 exposures on the regenerative, anti-inflammatory and metabolic qualities of hyperbaric therapy, as well as quality of life and cognitive benefits on otherwise healthy subjects. Multiple biomarkers will be tested throughout the study including epigenetic aging and telomere length.

Medicines called GLP-1 drugs lower blood sugar and help people with type 2 diabetes lose weight. Scientists compared one popular shot, semaglutide (Ozempic/Wegovy), with several similar drugs (liraglutide, exenatide, dulaglutide) and with the newer “twin” drug tirzepatide (Mounjaro/Zepbound). In five human studies, semaglutide beat the older GLP-1 drugs for weight loss and other health markers. However, tirzepatide helped people lose even more weight than semaglutide. Bottom line: semaglutide is the strongest of the first-generation GLP-1 medicines, but tirzepatide now leads the pack for weight control in type 2 diabetes.

Doterra is conducting multiple studies to evaluate the impact of their essential oils. The first study with a product called On Guard, which is an essential oil blend to support the immune system. Particular outcomes of interest include immune cell subset changes and quantification of multiple immune-regulated proteomic markers.

This was a prospective, clinical pilot study (n=20) to evaluate the impact of a ketamine treatment for Major Depressive Disorder (MDD) or Post Traumatic Stress Disorder (PTSD) on epigenetic aging. Epigenetic age acceleration has been found in patients with MDD, with a median of 2 years of excess cellular aging. Dose effects were noted with increasing depressive symptom severity and even more profound effects in the presence of childhood trauma. Similar effects have also been noted in patients with PTSD, alcohol dependence, and bipolar disorder. Sub-anesthetic doses of ketamine, a strongly anti-inflammatory NMDA receptor antagonist, have been demonstrated to rapidly reduce the symptoms of major depression, bipolar depression, and PTSD. Ketamine’s potential effects on epigenetic aging for individuals with depression or PTSD have not been investigated. This single group pilot study involved administering six doses of IV ketamine at 0.5 mg/kg within three weeks for patients with a diagnosis of MDD or PTSD. Pre- and post-treatment testing of biological age using the TruDiagnostic TruAge test was performed.

The objective of this study was to understand the impact of a polyphenol-rich supplement on measurements of epigenetic immune age and immune cell patterns germane to immune age over a 90-day period. The primary objective of this trial was to assess the effects of the supplement, HTB Rejuvenate, on immune age markers. The secondary objective of this trial was to assess the effects of the supplement, HTB Rejuvenate, on leukocyte immune profiles. Study Findings: Findings from this study didn’t show a significant change in biological aging among study participants. However, one important aspect of this study was that it was completely virtual.
